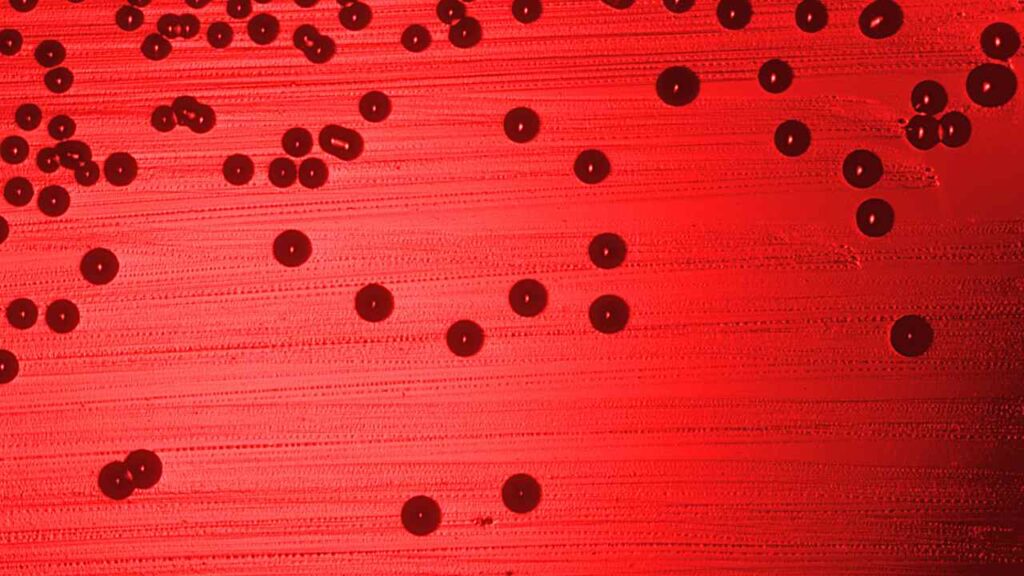
Meningite fulminante taranto

A Taranto un bimbo di soli tre anni è morto in ospedale, e i medici non sembrano avere dubbi che si tratti di meningite fulminante.
Una tragedia improvvisa ha scosso e addolorato l’intera comunità di Taranto: un bambino di soli tre anni infatti, è deceduto nelle prime ore della mattinata di ieri, 4 Settembre 2025, e i medici non sembrano più avere dubbi sul fatto che abbia contratto la meningite fulminante, una malattia che purtroppo, raramente lascia scampo a chi ne è affetto.
Tragedia a Taranto, bimbo di 3 anni muore in ospedale
Da quanto si apprende, il bimbo si era sentito male a casa costringendo i genitori a portarlo d’urgenza al Pronto Soccorso della Santissima Annunziata di Taranto, dove i medici hanno subito compreso quanto fosse grave il quadro clinico del piccolo. Purtroppo, nonostante le cure tempestive, non c’era più nulla da fare e il bibmo è morto lasciando i genitori in preda al dolore e allo sconforto.
Ma che cos’è la meningite fulminante che secondo i dottori ha causato la morte del piccolo?
Leggi anche: Chi è Edouard Rigaud, il compagno di Caterina Murino: età, carriera e il figlio appena nato
Che cos’è la meningite fulminante
Quindi parliamo di meningite fulminante, ci stiamo riferendo a un processo infiammatorio che va a colpire le membrane che avvolgono il nostro cervello e il midollo spinale. Queste membrane hanno lo scopo di proteggere il nostro sistema nervoso centrale dalle infezioni e quando queste vengono indebolite o annientate, come nel caso della meningite fulminante, il nostro corpo resta sprovvisto di qualunque tipo di difesa e anche l’infezione più semplice, rischia a quel punto di ucciderci.
Si capisce a questo punto perché si tratta di una malattia che purtroppo in tantissimi casi non può essere in alcun modo curata se non quando viene diagnosticata prontamente ai suoi esordi. Può inoltre essere contratta a qualunque età e diverse ricerche hanno dimostrato come la meningite fulminante si sviluppi a seguito di una meningite batterica.

Dal 2016 lavora nel mondo dell’editoria, del marketing e del giornalismo.